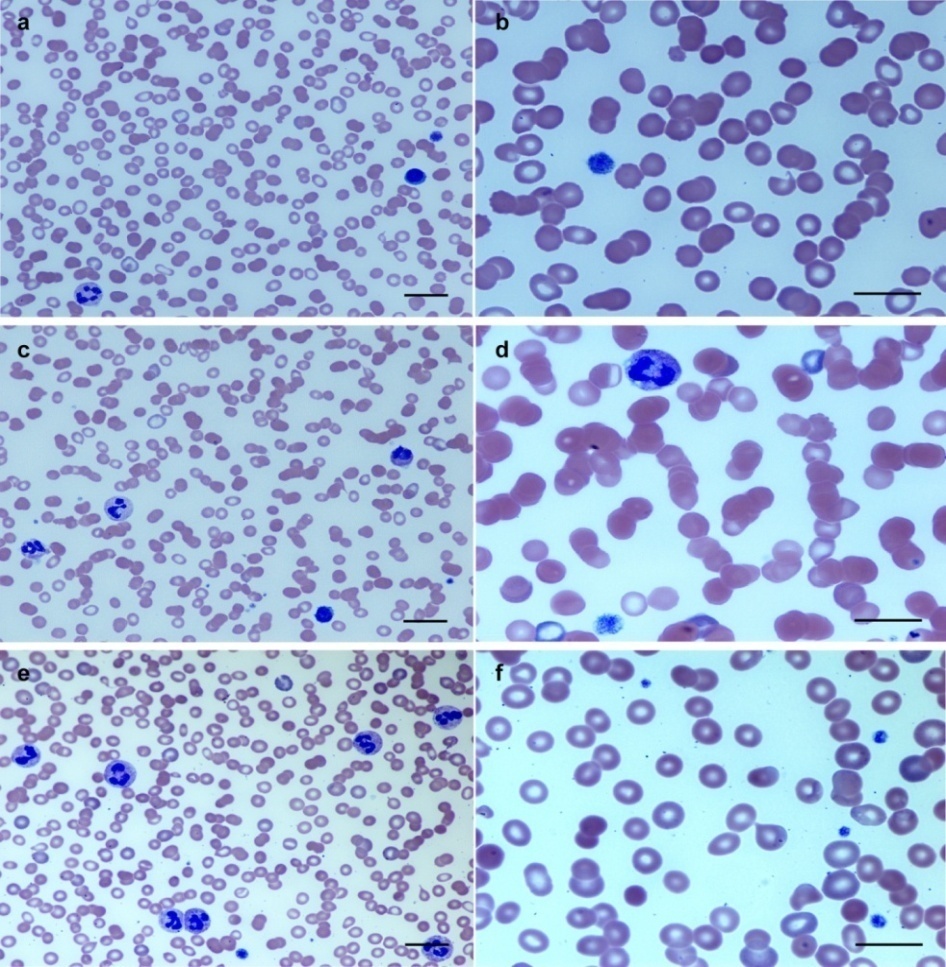

Int J Pharm Pharm Sci, Vol 7, Issue 7, 456-458Case Study
IMMUNE-MEDIATED ADALIMUMAB-INDUCED THROMBOCYTOPENIA FOR THE TREATMENT OF ULCERATIVE COLITIS
SUNYOUNG LEEa,*, MICHAEL CHARYb, ILNAZ SALEHIa, RAGHAV BANSALc
aDepartment of Medicine, Elmhurst Hospital Center, Icahn School of Medicine at Mount Sinai, Elmhurst, New York, United States of America, bIcahn School of Medicine at Mount Sinai, New York, New York, United States of America, cDivision of Gastroenterology, Department of Medicine, Elmhurst Hospital Center, Icahn School of Medicine at Mount Sinai, Elmhurst, New York, United States of America
Email: sunyoung.s.lee@mssm.edu
Received: 19 Feb 2015 Revised and Accepted: 22 May 2015
ABSTRACT
Objective: Tumor-necrosis factor (TNF)-α inhibitors including adalimumab have been widely used for patients with inflammatory bowel diseases refractory to conventional treatment. Neutropenia is the most common side effect of TNF-α inhibitors, but thrombocytopenia is rarely presented. Few cases have been reported on TNF-α-induced thrombocytopenia, but the pathophysiology has not been fully understood. Herein, we explore the pathophysiology of adalimumab-induced thrombocytopenia through the clinical course and treatment options for a patient that developed thrombocytopenia after administration of adalimumab.
Methods: We report a singular case of a patient with refractory ulcerative colitis who developed retinal hemorrhages due to thrombocytopenia after receiving adalimumab. The patient’s platelet count continued to drop despite discontinuation of adalimumab and platelet transfusion administration. Thrombocyopenia stabilized only after receiving intravenous immunoglobulin and prednisone. Laboratory tests identified anti-platelet IgM, but no antibody reactivity was seen against platelets in the presence of adalimumab (anti-platelet-adalimumab complex).
Results: The patient’s response to immunosuppressants and lack of antibody against adalimumab-platelet complexes (drug-induced thrombocytopenia or type II hypersensitivity reaction) suggests that adalimumab can induce destruction of platelets through the formation anti-platelet antibodies. This is likely caused by immune system derangement in the setting of a chronic inflammatory state, as seen with ulcerative colitis, including an antigenic mimicry of adalimumab against a surface epitope of platelets or adalimumab-induced T-cell apoptosis.
Conclusion: Physicians are to be aware of a life-threatening complication of adalimumab, immune-mediated thrombocytopenia for the treatment of ulcerative colitis.
Keywords: Ulcerative colitis, Adalimumab, TNF-α inhibitor, Thrombocytopenia.
INTRODUCTION
The release of tissue necrosis factor (TNF)-α is important in the pathophysiology of inflammatory diseases such as rheumatoid arthritis, seronegative spondyloarthropathies, Crohn’s disease, and ulcerative colitis [1-3]. The FDA has approved five TNF-α inhibitors for the treatment of a variety of inflammatory illnesses-etanercept, infliximab, adalimumab, certolizumab pegol, and golimumab. Treatment for ulcerative colitis primarily involves 5-aminosalicylates or azathioprine but can include TNF-α inhibitors if the disease fails to respond to those treatments. Adverse effects of TNF-α inhibitors includes anaphylactic reactions, infection, lymphoma, thrombocytopenia, congestive heart failure, lupus-like syndrome, and demyelinating disease [4]. The most common adverse hematological side effect is neutropenia [5]. Therefore, TNF-α inhibitors are not recommended for patients with active bacterial, viral, or fungal infections [6].
Thrombocytopenia is a rarely reported adverse effect of TNF-α inhibitors. Few cases have been reported on TNF-α-induced thrombocytopenia, but the risk factors for, and underlying mechanism of, TNF-α inhibitor-induced thrombocytopenia are poorly understood. As TNF-α inhibitors come into increasing use, it is important to understand adverse events and pathophysiology.
Herein, we report a case of a patient with refractory ulcerative colitis who developed thrombocytopenia and retinal hemorrhage after treatment with adalimumab. We discuss the patient’s clinical course and the pathophysiology of adalimumab-induced thrombocytopenia.
Case report
A 26 year-old man with a past medical history of ulcerative colitis, diagnosed three and a half years ago via colonoscopy and biopsy presented for bilateral constant blurry vision in the context of recently starting adalimumab. The patient began treatment with 4.8 g of mesalamine each day, which initially reduced his symptoms. However, the patient was started on azathioprine because of his worsening symptoms. As the patient’s symptoms were not controlled by the addition of azathioprine, it was discontinued, and the patient was started on infliximab.
The patient’s symptoms underwent remission with infliximab, but he began to experience a cascade of side effects including severe joint pain in the bilateral lower extremities and shortness of breath. As the side effects became debilitating and thought to be secondary to a delayed infusion reaction, infliximab was discontinued. At this point, laboratory work did not show any evidence of thrombocytopenia. The patient remained free of any standing medications for two years and received mesalamine and steroids for any acute flares.
The patient’s symptoms gradually worsened. Two and one-half months before presentation, the patient resumed medical treatment with adalimumab administered subcutaneously every two to three weeks. At this point, the patient’s symptoms improved. His platelet count was 207,000/mm3. Twenty days after the last dose of adalimumab, the patient experienced constant bilateral blurry vision on wakening with no other neurological symptoms. He was found to have superficial bilateral retinal hemorrhages with a platelet count of 3,000/mm3 in the office of the patient’s primary retinal specialist.
The patient was admitted to the hospital with an unremarkable physical initial examination. He was found to have a hemoglobin of 0.41 mmol/l (7.4 g/dL), mean corpuscular volume of 78-79 fL, iron of 1,020.8 nmol/l (37 µg/dL), ferritin of 5 ng/ml, and total iron binding capacity of 7,449.3 nmol/l (270 µg/dL). The patient received two units of platelet transfusion, which increased the platelet count to 25,000/mm3 (see fig. 1 for platelet counts after admission). The patient’s platelets dropped again to 8,000/mm3the next day. He received another two units of platelets, which again, temporarily increased his platelet count to 29,000/mm3. It subsequently dropped to 7,000/mm3 and a peripheral blood smear demonstrated giant platelets (fig. 2a and b).
To explore the possibility and pathophysiology of thrombo cytopenia, various blood tests were performed. Laboratory studies identified an anti-platelet IgM antibody, but no antibody reactivity against platelets in the presence of infliximab and adalimumab (antibody against platelet-infliximab and platelet-adalimumab complexes) were detected. Anti-nuclear antibody, anti-DNA antibody, and anti-cardiolipin antibody all tested negative. Thyroid stimulating hormone, vitamin B12, and folic acid level was within normal limits. Human immunodeficiency virus (HIV) test, Helicobacter pylori antigen, and hepatitis C antibody was negative. A direct antiglobulin test (DAT) was negative, and bilirubin, haptoglobin, and lactate dehydrogenase (LDH) levels were within normal limits.
With a leading diagnosis of immune-mediated thrombocytopenia, the patient received 1 g/kg of intravenous immunoglobulin (IVIG) for two days along with another two units of platelet transfusion. The platelet count was maintained between 10,000-17,000/mm3. A second peripheral smear demonstrated more giant platelets and appreciable rouleaux formation (fig. 2c and d).
The rouleaux formation was considered a result of IVIG. The patient was started on 1 mg/kg prednisone each day. On the third day of prednisone treatment, the patient’s platelet count rose to 55,000/mm3and was maintained at 20,000–50,000/mm3 (fig. 2e and f). The patient’s platelet count remained stable on prednisone, and the patient was discharged with a platelet count of 46,000/mm3. Two months later, his platelet count was 190,000/mm3on a prednisone taper.

Fig. 1: Platelet counts after hospital admission. The patient received 2 units of platelet transfusion on hospital day 1, 3, and 5; intravenous immunoglobulin, on day 5 and 6; and prednisone was started on day 7
DISCUSSION
TNF-α inhibitors often cause neutropenia, but only a few cases of thrombocytopenia have been reported with no clear pathophysiology. This patient received infliximab and adalimumab, but developed thrombocytopenia only after receiving adalimumab.
Secondary immune thrombocytopenia (ITP) was ruled out by negative anti-nuclear antibody, anti-DNA antibody, anti-cardiolipin antibody, HIV test, Helicobacter pylori test, and hepatitis C antibody, as well as thyroid stimulating hormone, vitamin B12, and folic acid level within normal limits. Therefore, TNF-α inhibitor-induced thrombocytopenia was diagnosed.
Fig. 2: Peripheral blood smears (Wright’s staining) of this patient with adalimumab-induced thrombocytopenia. a and b: Slides with platelet count of 3,000/mm3 before any interventions. c and d: Smears after the patient received IVIG 1 g/kg/d for 2 days with platelet count of 17,000/mm3. e and f: Smears at discharge after the patient finished IVIG 1 g/kg/d for 2 days, followed by prednisone 70 mg with platelet count of 46,000/mm3. Scale bars = 30 µm (x 400) in a, c, and e. Scale bars = 20 µm (x1,000) in b, d, and f
The pathophysiology of TNF-α inhibitor-induced thrombocytopenia is poorly understood. Three possible mechanisms could be suggested: 1) bone marrow suppression and destruction of megakaryocytes or stem cells from direct toxicity of adalimumab [7,8], 2) formation of antibodies against a new epitope on the drug-platelet complex and destruction of platelets only in the presence of the drug (drug-induced thrombocytopenia (DITP) or type II hypersensitivity reaction) [9, 10], and 3) an immune system derangement and associated formation of autoantibodies against platelets, which does not require the presence of the drug [5, 11].
Direct bone marrow toxicity of adalimumab is unlikely to explain this parent’s thrombocytopenia. Peripheral blood smears from the patient revealed many giant platelets as shown in fig. 2a and b. This suggests that the bone marrow was active and trying to compensate for an increased rate of destruction of platelets.
A type II hypersensitivity reaction or DITP is also unlikely; the platelet count did not normalize when adalimumab was discontinued. In addition, the patient’s serum demonstrated no antibody reactivity against platelets in the presence of infliximab or adalimumab. Drugs could make a non-covalent binding with platelets, creating a new epitope in the drug-platelet complex. Antibodies specific for this new epitope do not bind to platelets in the absence of the medication. Other medications including vancomycin [12] or acetaminophen [13] were reported to develop drug-specific antibodies causing DITP. Only when platelets were mixed with vancomycin or acetaminophen did antibodies show reactivity against platelets.
Platelet counts continued to drop despite repeated platelet transfusions and discontinuation of adalimumab but were held constant after receiving IVIG and prednisone. This strongly implies that the destruction of platelets did not require the presence of adalimumab and that the etiology was immune-mediated. This is supported by the presence of anti-platelet IgM.
This demonstrates a similar pathophysiology to that reported in patients who received alemtuzumab for the treatment of multiple sclerosis: Cuker et al. [14] reported a distinct form of immune thrombocytopenia (ITP-like syndrome) with persistent thrombocytopenia despite discontinuation of alemtuzumab, but thrombocytopenia resolved after steroid treatment.
The presence of anti-platelet IgM is most likely a result of immune system derangement: an antigenic mimicry of adalimumab against a surface epitope of platelets [15] or adalimumab-induced T-cell apoptosis and modification [5] in the setting of a chronic inflammatory state, such as ulcerative colitis.
CONFLICT OF INTERESTS
Authors declare no conflicts of interest
REFERENCES
- Benucci M, Saviola G, Manfredi M, Sarzi-Puttini P, Atzeni F. Tumor necrosis factors blocking agents: analogies and differences. Acta Biomed 2012;83:72-80.
- Peyrin-Biroulet. Tumor necrosis factor inhibitors for inflammatory bowel disease. N Engl J Med 2013;369:2561.
- Caramaschi P, Bambara LM, Pieropan S, Tinazzi I, Volpe A, Biasi D. Anti-TNFalpha blockers, autoantibodies and autoimmune diseases. Jt Bone Spine 2009;76:333-42.
- Scheinfeld N. A comprehensive review and evaluation of the side effects of the tumor necrosis factor alpha blockers etanercept, infliximab and adalimumab. J Dermatolog Treat 2004;15:280-94.
- Bessissow T, Renard M, Hoffman I, Vermeire S, Rutgeerts P, Van Assche G. Review article: non-malignant haematological complications of anti-tumour necrosis factor alpha therapy. Aliment Pharmacol Ther 2012;36:312-23.
- Saag KG, Teng GG, Patkar NM, Anuntiyo J, Finney C, Curtis JR, et al. American college of rheumatology. american college of rheumatology 2008 recommendations for the use of nonbiologic and biologic disease-modifying antirheumatic drugs in rheumatoid arthritis. Arthritis Rheum 2008;59:762-84.
- Visentin GP, Liu CY. Drug-induced thrombocytopenia. Hematol Oncol Clin North Am 2007;21:685-96.
- Andres E, Dali-Youcef N, Serraj K, Zimmer J. Recognition and management of drug-induced cytopenias: the example of idiosyncratic drug-induced thrombocytopenia. Expert Opin Drug Saf 2009;8:183-90.
- Aster RH, Bougie DW. Drug-induced immune thrombocytopenia. N Engl J Med 2007;357:580-7.
- Aster RH, Curtis BR, McFarland JG, Bougie DW. Drug-induced immune thrombocytopenia: pathogenesis, diagnosis, and management. J Thromb Haemost 2009;7:911-8.
- Hamaguchi M, Kawahito Y, Ishino H, Yoshida M, Yoshikawa T. A case report of tumor necrosis factor-alpha antibody-induced thrombocytopenia associated with emerging IgM anticardiolipin antibody in patients with scleroderma overlap/rheumatoid arthritis. Clin Rheumatol 2007;26:988-90.
- Von Drygalski A, Curtis BR, Bougie DW, McFarland JG, Ahl S, Limbu I, et al. Vancomycin-induced immune thrombocytopenia. N Engl J Med 2007;356:904-10.
- Bougie DW, Benito AI, Sanchez-Abarca LI, Torres R, Birenbaum J, Aster RH. Acute thrombocytopenia caused by sensitivity to the glucuronide conjugate of acetaminophen. Blood 2007;109:3608-9.
- Cuker A, Coles AJ, Sullivan H, Fox E, Goldberg M, Oyuela P, et al. A distinctive form of immune thrombocytopenia in a phase 2 study of alemtuzumab for the treatment of relapsing-remitting multiple sclerosis. Blood 2011;118:6299-305.
- Zlatanic J, Korelitz BI, Wisch N, Kim P, Ammirati M, Schwarz S, et al. Inflammatory bowel disease and immune thrombocytopenic purpura: is there a correlation? Am J Gastroenterol 1997;92:2285-8.